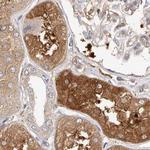
LAP3 Antibody in Immunohistochemistry (IHC)

Search
Invitrogen
LAP3 Polyclonal Antibody
{{$productOrderCtrl.translations['antibody.pdp.commerceCard.promotion.promotions']}}
{{$productOrderCtrl.translations['antibody.pdp.commerceCard.promotion.viewpromo']}}
{{$productOrderCtrl.translations['antibody.pdp.commerceCard.promotion.promocode']}}: {{promo.promoCode}} {{promo.promoTitle}} {{promo.promoDescription}}. {{$productOrderCtrl.translations['antibody.pdp.commerceCard.promotion.learnmore']}}
产品信息
PA5-56206
种属反应
宿主/亚型
分类
类型
抗原
偶联物
形式
浓度
规格
纯化类型
保存液
内含物
保存条件
运输条件
RRID
产品详细信息
Immunogen sequence: AGRVVVRRLA VRRFGSRSLS TADMTKGLVL GIYSKEKEDD VPQFTSAGEN FDKLLAGKLR ETLNISGPPL KAGKTRTFYG LHQDFPSVVL VG
Highest antigen sequence identity to the following orthologs: Mouse - 79%, Rat - 82%.
靶标信息
Leucine Aminopeptidase 3 (LAP3) is involved in the processing and regular turnover of intracellular proteins. It catalyzes the removal of unsubstituted N-terminal amino acids from various peptides. Release of an N-terminal amino acid, Xaa-/-Yaa-, in which Xaa is preferably Leu, but may be other amino acids including Pro although not Arg or Lys, and Yaa may be Pro. Amino acid amides and methyl esters are also readily hydrolyzed, but reated on arylamides are exceedingly low.
仅用于科研。不用于诊断过程。未经明确授权不得转售。
篇参考文献 (0)
生物信息学
蛋白别名: Cysteinylglycine-S-conjugate dipeptidase; Cytosol aminopeptidase; epididymis secretory protein Li 106; LAP-3; LAP3; Leucine aminopeptidase 3; Leucyl aminopeptidase; Peptidase S; Proline aminopeptidase; Prolyl aminopeptidase; unnamed protein product
基因别名: HEL-S-106; LAP; LAP3; LAPEP; PEPS
UniProt ID: (Human) P28838
Entrez Gene ID: (Human) 51056